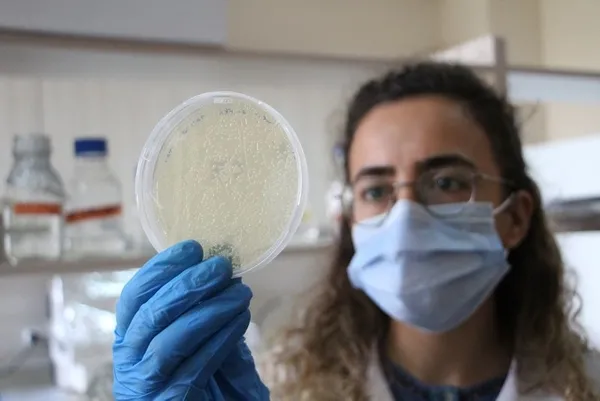
Koronavirüs mutasyonunun adı açıklandı! Hazırlanan raporda mutasyona verilen isim...

Koronavirüs mutasyonunun adı açıklandı! Hazırlanan raporda mutasyona verilen isim...

Koronavirüsün mutasyona uğradığı haberi korku saldı. Yeni koronavirüs mutasyonu hakkında Avrupa Hastalık Kontrol Merkezi tarafından hazırlanan raporda ismine de yer verildi. İşte koronavirüs mutasyonunun ismi.
Avrupa Hastalık Kontrol Merkezi, koronavirüsün mutasyona uğraması sonucu yapılan araştırmanın raporunu açıkladı. Söz konusu raporda mutasyona uğrayan koronavirüse verilen isim dikkat çekti.

Avrupa Kontrol Merkezince yayımlanan raporda, dünyayı sarsan yeni tip koronavirüsün (Kovid-19) İngiltere'de mutasyona uğrayarak daha hızlı yayılan bir tipine "SARS-CoV-2 VUI 202012/01 (Variant Under Investigation, year 2020, month 12, variant 01) ismi verildiği ve etkilerinin araştırılmaya başlandığı bildirildi.

Ankara Üniversitesi (AÜ) Tıp Fakültesi Enfeksiyon Hastalıkları Anabilim Dalı Başkanı Prof. Dr. İsmail Balık, AA muhabirine yaptığı açıklamada, Kovid-19'un, İngiltere'de yüzde 70 artırabilen mutasyonlara uğradığı ancak hastalık yapma özelliğinde bir değişiklik yapmadığı yönündeki açıklamalara ilişkin değerlendirmelerde bulundu.

Koronavirüs ailesinde yer alan Kovid-19'un yıl içinde çok kez mutasyona uğrağını anımsatan Balık, ancak kesin bilgilerin yapılacak bilimsel incelemeler ile tam olarak netlik kazanabileceğini söyledi.
Balık, İngiltere'den bildirilen mutasyonla ilgili dün gece yarısı Avrupa Hastalık Kontrol Merkezince rapor yayımlandığını vurgulayarak, "Bu mutanta şimdilik SARS-CoV-2 VUI 202012/01 (Variant Under Investigation, year 2020, month 12, variant 01) ismi verildi." ifadelerini kullandı.

Kovid-19'un mutasyona uğrayarak daha hızlı yayılan tipine ilişkin kapsamlı inceleme yapılmasının önemine işaret edilen raporda, ilgili virüsün araştırılmaya başlandığını ifade eden Balık, şu bilgileri verdi:

"Mutasyona uğrayarak daha hızlı yayılan bir tip olan virüse ilişkin inceleme yapılıyor. Bu kapsamda, 'Virüs, hangi ülkelere yayılıyor?', "Piyasadaki PCR testleri ile tespitten kaçıyor mu?', 'Kullanılan antikor ya da plazma tedavilerinden etkilenmiyor mu?', 'Halihazırdaki aşıları etkisiz bırakacak mı?', 'Daha ağır hastalık yapacak mı?', 'Hastalığı geçirmiş olanlarda ikinci enfeksiyon geçirilme oranını artıracak mı?' başlıklarında araştırılıyor."

Virüsün İngiltere dışında başka ülkelerde de görüldüğünün raporlandığına işaret eden Balık, "Şu ana kadar Hollanda, Belçika Danimarka ve Avustralya'da da tespit edildiği raporda yer aldı." dedi.

"VİRÜSTE 'ÇOKLU SPİKE PROTEİNİ MUTASYONU' TESPİT EDİLDİ"
Prof. Dr. Balık, "Bu mutasyonun İngiltere'de son günlerdeki salgının büyümesine etki ettiği düşünülmektedir." bilgisinin de raporda yazıldığına değindi.

Daha hızlı yayılan bir tip olan virüste "Çoklu spike protein mutasyonu" tespit edildiğini aktaran Balık, şöyle konuştu:
"Çoklu spike protein mutasyonu, virüsün insan hücresine girmesini sağlayan dıştaki dikensi kısmında birçok noktada mutasyon olması. Daha önce görülen mutasyonlar genelde tek noktada olmuştu. Şu anki bilgiler bu yeni mutantın eski virüsten fazla farkının olmadığı, sadece bulaşma gücünü artırdığını göstermektedir."

Sağlık Bakanı Fahrettin Koca, gelişmeler üzerine dün gece İngiltere, Danimarka, Hollanda ve Güney Afrika'dan Türkiye'ye uçuşlarda geçici durdurma kararı alındığını bildirmişti.

Sosyal medya hesabından açıklama yapan Koca, "Koronavirüsün mutasyonuyla İngiltere'de bulaş hızının arttığı bildirilmiştir. Cumhurbaşkanımızın talimatı, Ulaştırma ve Altyapı Bakanlığımızın koordinasyonu ile tedbiren İngiltere, Danimarka, Hollanda ve Güney Afrika'dan ülkemize olan uçuşlarda geçici durdurma kararı alınmıştır." açıklamasında bulunmuştu.

Koca ayrıca, İngiltere kaynaklı mutasyon riski üzerine alınan tedbirler kapsamında halen yolda olan uçuşlar için tüm yolculara test yapılacağını ve karantina kurallarının uygulanacağına da değinmişti. Bu kapsamda Sağlık Bakanı Koca, "İngiltere kaynaklı mutasyon riski üzerine alınan tedbirler kapsamında halen yolda olan uçuşlar için tüm yolculara test yapılacak ve karantina kuralları uygulanacaktır. Tedbirler tam koordinasyonla yürütülmektedir." paylaşımında bulunmuştu.

 GÜNÜN MANŞETLERİ İÇİN TIKLAYIN
GÜNÜN MANŞETLERİ İÇİN TIKLAYIN








